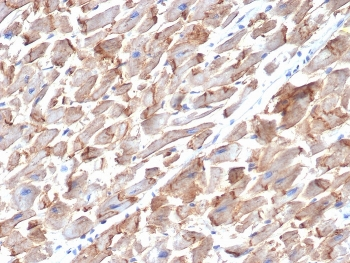
N-Cadherin Antibody / CDH2

You have no items in your shopping cart.
Search results for: 'N-cadherin (CDH2)'
- N Cadherin Rabbit mAb [orb1563080]Featured

IP, WB
Human, Mouse, Rat
Monoclonal
Unconjugated
100 μl, 50 μl, 20 μl - N-Cadherin / Cadherin-2 / CD325 (NCAD) Antibody [orb389106]
FC, IF, WB
Human, Mouse
Mouse
Monoclonal
Unconjugated
100 μg (without BSA and Azide), 100 μg, 20 μg

![N-Cadherin Antibody [13A9]](/images/pub/media/catalog/product/NewWebsite/15/orb1252211_1.jpg)
![N-Cadherin Antibody [13A9]](/images/pub/media/catalog/product/NewWebsite/15/orb1252211_2.jpg)
